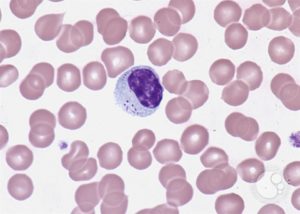
Атипичные лимфоциты и плазматические клетки

Атипичные лимфоциты: норма в анализе крови у взрослых и детей, причины повышения
Противостоять болезням организму помогают антитела. Их выработка происходит в костном мозге. Здесь идёт созревание лимфоцитов, нейтрофилов, базофилов, эозинофилов, моноцитов. Больше всего образуется лимфоцитов – главных борцов иммунной системы, которые занимаются защитой организма.
Наряду с ними существуют клетки с особыми параметрами, функциями. Атипичные лимфоциты – это разновидность иммунных тел. Причиной их появления становятся аллергические реакции, инфекции. Воздействие патогенных организмов меняет их структуру, форму. При нормальном состоянии человека они отсутствуют.
Разного рода заболевания провоцируют их появление.
Особенности
Атипичный или реактивный лимфоцит имеет особенности. Его отличают:
- Форма неправильного многоугольника с рваными краями. Для здорового лейкоцита характерны ровные границы, округлость.
- Увеличение размера. Самыми крупными лейкоцитами являются макрофаги. Их размер достигает 12 мкм. Для лимфоцитов характерен небольшой размер. Они увеличиваются под влиянием вирусов и достигают 30 мкм.
- Клеточное ядро вытягивается, становится продолговатым. При исследовании под микроскопом видны трещины.
- Окрашивание в яркий цвет при анализе с использованием гематоксилина и эозина. Клетки меняют окрас на синий, иногда на тёмно-серый. Цвет ядра становится фиолетовым.
Чтобы выявить присутствие аномальных клеток, анализируют состав крови, так как она содержит большое число иммунных тел. Ткани организма аккумулируют их в меньшем количестве.
Разновидности
Структура клетки меняется под воздействием микроорганизмов. Как результат, полностью меняются её функции и параметры.
Дегенеративные
Период длительной интоксикации приводит к образованию дегенеративных клеток, которые не способны делиться и функционировать из-за скопившихся токсинов. Их размер уменьшается либо увеличивается. Виновниками изменений называют дистрофию печени, сепсис, абсцесс.
Клетки Дауни
Размер атипичных мононуклеаров больше, чем здоровых лимфоцитов. Для них характерно наличие моноцитарного ядра. Лимфомоноциты являются показателем наличия вирусной инфекции. Чаще всего это герпес либо мононуклеоз. Выздоровление приводит к нормализации состава крови.
В крови у детей атипичные мононуклеары присутствуют в количестве не более 1%. Показатели могут быть повышены из-за недавно перенесённых болезней или прививки. У взрослых их также обнаруживают.
Появление таких клеток связывают с ростом вероятности заражения герпесом или проявлением аллергии.
Клетки-тени Боткина-Клейна-Гумпрехта
Это понятие включает разрушенные лимфоидные клетки, полученные при подготовке исследуемого материала к анализу. Это значит, что кровяные тельца подвержены быстрому разрушению. Из-за сложности обнаружения они названы тенями. Характерно для хронического лимфолейкоза.
Клетки Ридера
Обнаружение почкообразных клеток с ядрами, имеющими зазубренный контур, сигнализирует о серьёзных заболеваниях. Чаще всего человек болен лейкемией, пернициозной анемией, тяжёлыми инфекциями.
Что вызывает появление
При обследовании обнаруживают атипичные лимфоциты в анализе крови даже при отсутствии жалоб.
При развитии болезни их число растёт, попутно появляются новые атипичные клетки, главными виновниками возникновения которых становятся инфекции вирусного происхождения, аллергия. Попадание микробов внутрь организма провоцирует защитную реакцию иммунной системы.
Начинается выработка антител для борьбы с возбудителем заболевания. При сниженной иммунной защите созревание может не произойти, клетка видоизменяется, приобретает иные качества.
Превышение нормы содержания в крови лимфоцитов, а также образование атипичных клеток может возникать при наличии рака. Наряду с ним существуют другие причины. Самая частая – инфекции, а также аллергия, от которой страдают жители мегаполисов. Приумножение числа лимфоцитов ведёт к лимфоцитозу.
Выявление клеток с нетипичными свойствами ассоциируется с опасными болезнями. Известны четыре основных группы факторов, влияющих на их возникновение:
- Присутствие в организме инфекций, вызванных вирусами, бактериями.
- Последствия интоксикации.
- Радиационное воздействие.
- Онкологические заболевания, наличие генетических патологий.
Нетипичные лимфоцитарные клетки образуются, если человек болен:
- Бруцеллёзом – заболеванием домашних животных, передающимся людям. Недуг протекает с поражением нервной системы, сердца, сосудов, костей, суставов.
- Лимфолейкозом – онкологией, при которой злокачественные клетки поражают ткани лимфы.
- Сифилисом – венерическим заболеванием с поражением кожных, слизистых покровов. Болезнь ухудшает состояние костной ткани, осложняет работу органов и систем.
- Токсоплазмозом – бессимптомной инфекцией, вызванной токсоплазмами. Источником заражения становятся кошки.
Лекарства и сыворотки, имеющие животное происхождение, также способствуют формированию реактивных лимфоцитов. У ребёнка этот процесс вызывают менингококковая инфекция, коклюш, корь, ряд других заболеваний.
Диагностика выявляет присутствие атипичных лимфоцитов у здоровых людей. Даже если взрослый человек не жалуется на проявления болезней, ему рекомендуют обратиться за консультацией к гематологу.
Реактивные лимфоциты в детском возрасте
Обозначение нормы состава крови детей и взрослых отличается. В организме здорового ребёнка отсутствуют атипичные лимфоциты. Часто причиной их появления становится мононуклеоз. При этой болезни нарушается целостность лейкоцитов, меняется состав их ядра. В результате иммунитет ослабевает, ребёнок заражается инфекциями.
Причинами лимфоцитоза у детей считают:
- вирусный гепатит;
- приём лекарств, таких как Тетрациклин;
- дефицит витаминов и минералов;
- проблемы пищеварительных органов;
- ветрянку, корь, скарлатину.
Ускорить выздоровление, избежать осложнений помогает ранняя диагностика. Выявить наличие проблемы способен анализ крови. Известный педиатр Комаровский рекомендует проводить такое исследование минимум один раз в год. Это позволит иметь сравнительные данные о составе крови, когда ребёнок здоров, а также во время болезни.
Симптомы
Атипичные лимфоциты никак не проявляются. Симптоматика возникает, когда болезнь поражает органы. Родители отмечают у детей:
- повышение температуры;
- появление сонливости, слабости;
- распространение инфекции на органы дыхания.
В ряде случаев появляются высыпания, кожа начинает зудеть. Отсутствие лечения ухудшает состояние. Требуется получить медицинскую помощь.
Лечение
Для нормализации состояния врачи проводят комплексную терапию:
- Лимфоцитарными препаратами снижают уровень лимфоцитов.
- Противовирусными, противовоспалительными средствами, антибиотиками борются с вирусами, инфекциями.
- Подбирают диету. Рекомендуют питание с высоким содержанием витаминов, микроэлементов. Ограничивают потребление жиров, соли.
- С онкологическими заболеваниями борются проведением курса химиотерапии.
Допустимые значения
Присутствие атипичных лимфоцитов допустимо у совершенно здорового человека, их норма – менее 6%. Повышенные показатели говорят о развитии патологии, необходимости начать лечение. В такой ситуации врач проводит диагностику и обследование. Для выбора лечения выясняют первопричину недуга.
Часто рекомендуют употреблять витамины, минералы, чтобы укрепить иммунитет. Заболевание вирусного характера лечат противовирусными препаратами. Аллергию устраняют противогистаминными, антиаллергенными средствами. Врачи советуют придерживаться диеты, исключить вредные привычки.
Клетки с атипичными свойствами в организме сигнализируют о проникновении вируса, развитии патологии. Обращение в поликлинику поможет выявить причину и устранить её.
Плазматические клетки в общем анализе крови: причины и лечение
Плазматические клетки — уникальное оружие иммунной системы, которое ожидает своего часа до вторжения чужеродных частиц в организм. Как только поступает сигнал о появлении бактерии или вируса, эти клетки начинают вырабатывать множество антител для нейтрализации вредоносного объекта.
Механизм появления плазматических клеток
Функция плазматических клеток — защитная
В отличие от других клеток иммунитета, плазматические не присутствуют в крови постоянно. Они содержатся преимущественно в лимфатических тканях, селезёнке и костном мозге, покидая свои убежища только в случае опасности для организма. Основной их функцией является выработка антител.
Механизм появления происходит следующим образом:
- иммунные клетки подают сигнал мозгу о том, что внедрились патогенные организмы определённого вида;
- мозг подаёт сигнал В-лимфоцитам с информацией о том, какой именно вирус либо бактерия проникла;
- В-лимфоциты перемещаются в лимфатические узлы, где перестраиваются в плазмоциты (плазматические клетки) для борьбы с конкретным возбудителем болезни;
- плазмоциты начинают выработку иммунного ответа, образуя за секунду несколько тысяч молекул белковых соединений — антител.
В процессе трансформации В-лимфоцитов часть новообразовавшихся клеток переходит в так называемые клетки памяти. Они живут десятилетиями в костном мозге, неся в себе антитела против каждой бактерии или вируса. Плазмоциты же погибают в течение несколько дней после зарождения.
Причины плазмоцитов в анализе крови
Инфицирование организма может привести к появлению плазмоцитов
Таким образом, плазмоциты появляются в кровяном русле только в случае необходимости выработки антител. При отсутствии патогенного фактора в плазматических клетках потребности нет. Если в образце крови обнаружены трансформировавшиеся В-лимфоциты, значит в организме присутствует инфекция, либо присутствовала в недавнем прошлом.
Факторы, провоцирующие образование плазмоцитов:
- грипп,
- ОРЗ,
- ОРВИ,
- заражение бактериями,
- инфекционные заболевания,
- мононуклеоз,
- туберкулёз,
- дисбактериоз,
- патологии аутоиммунного характера,
- онкологические поражения тканей.
Когда наличие плазматических клеток — норма?
Плазмоциты некоторое время могут циркулировать после инфекции
У здорового взрослого человека плазмоциты не должны присутствовать в кровяном потоке. Они могут появляться в соотношении 1-2 на 1000 лейкоцитов, поэтому при диагностировании образца крови чаще всего не обнаруживаются.
После перенесённого заболевания трансформированные клетки продолжают некоторое время циркулировать в плазме. Поэтому в случае обнаружения плазмоцитов, необходимо пересдать анализ через несколько дней.
Для детей наличие небольшого процента плазматических клеток — норма. Начиная с 5-го дня жизни и до окончания периода полового созревания в крови может содержаться от 0,25 до 0,5% плазмоцитов. Процентное значение рассчитывается в соотношении к общему числу лейкоцитов.
Тест на выявление плазмоцитов
Тест на определение плазмоцитов требует минимальной подготовки
Врач может направить на анализ по выявлению плазмоцитов, если пациента беспокоят различные недомогания: ломота в суставах, вялость, беспричинная усталость, субфебрильная температура, болевые ощущения в области живота, увеличение лимфатических узлов.

Плазмоциты выявляются во время проведения общего анализа крови. Чаще всего образец крови берут из пальца, реже из вены. Перед изъятием крови рекомендуется не употреблять пищу в течение 8 часов.
Если в результате анализа обнаружилось присутствие плазмоцитов, необходимо пройти дополнительные обследования, чтобы установить причину. Только после этого врач назначает лечение.
Факторы, влияющие на результат
Плазмоциты в образце крови у детей — не редкость
Наличие у взрослых плазмоцитов — это явный знак патологического процесса в организме. Если острой стадии болезни при этом не наблюдается, врач может заподозрить вялотекущее хроническое инфицирование, которое может никак не проявляться внешне. Последующее исследование выявит фактор, повлиявший на появление плазматических клеток.
У детей иммунная система только формируется, сталкиваясь с множеством вирусов, грибов и бактерий. Для создания стойкого иммунитета на всю жизнь, белые кровяные клетки активно вырабатывают ответ на каждый опасный объект. В образце крови ребёнка постоянно можно обнаружить плазмоциты. Поэтому возраст пациента является одним из факторов, влияющих на результат.
Повышение количества трансформированных клеток выявляется после проведения вакцинации. Именно при помощи плазмоцитов и клеток памяти образуется иммунный ответ на введённые в организм частицы вируса, что позволяет клеткам дать отпор этому вирусу в будущем.
Угроза наличия плазмоцитов
Мазок крови у пациента с плазмоцитомой
Само по себе наличие плазмоцитов является следствием воспалительного процесса в организме. Если болезнетворную причину устранить, клетки не будут больше циркулировать в крови. Однако, под действием некоторых факторов, плазмоциты могут сформироваться неправильно и превратиться из друзей иммунной системы в её врагов.
Это явление — наиболее частое опасение пациентов, получивших на руки бланк о содержании плазмоцитов в крови.
Представление, что все плазмоциты представляют угрозу и являются показателем онкологических изменений в крови, является ошибочным.
Такой сбой на одной из стадий трансформации В-лимфоцита в плазмоцит происходит в редких случаях, возможной причиной может послужить токсическое поражение организма, воздействие радиации, генетические нарушения.
В результате сбоя появляется атипичная плазматическая клетка, которая путём беспрерывного деления образует плазмоцитому. Новообразование представляет собой злокачественную опухоль плазматических клеток и несёт опасность для жизни человека.
Лечение и профилактика
Лечение направлено на причину, вызвавшую появление плазмоцитов
Лечение заключается в определении и устранении причины, вызвавшей появление в крови плазматических клеток. В зависимости от факторов, спровоцировавших образование плазмоцитов назначаются препараты:
- противовирусные,
- антибактериальные,
- антибиотики,
- антигистаминные,
- глистогонные,
- витаминные комплексы.
В случае формирования скопления атипичных плазмоцитов, может понадобится лучевая и химиотерапия, применение глюкокортикостероидов, хирургическое вмешательство.
Профилактические меры включают в себя сбалансированное питание, полноценный отдых, отсутствие физических и эмоциональных перенапряжений. Важной составляющей является отсутствие недолеченных заболеваний, во избежание их перетекания в хронические формы.
Атипичные лимфоциты: норма и причины появления атипичныех лимфоцитов в анализе крови
Не секрет, что за борьбу с болезнями в нашем организме отвечают крохотные тельца, называемые антителами. За их выработку отвечает красный костный мозг — орган кроветворения, в недрах которого созревают новенькие иммунные клетки: лимфоциты, нейтрофилы, базофилы, эозинофилы и моноциты.
Главнейшим агентом иммунного ответа являются лимфоциты — их численность в крови преобладает над всеми остальными, именно с помощью них организм ведёт основную борьбу с инфекцией. Большинство лимфоцитов имеет правильную круглую форму и чёткие контуры, однако есть клетки, параметры которых немного отличаются от «оригинала». Такие клетки учёные называют атипичными.
Атипичные или реактивные лимфоциты — это особые иммунные тела, появляющиеся при аллергических реакциях, инфекционных и других заболеваниях. Неправильная форма и размер клеток обусловлены воздействием патогенных микроорганизмов, полностью меняющих их структуру. В норме атипичные иммунные тела не должны появляться вообще, а их наличие может указывать на развитие различных заболеваний.
В этой статье мы расскажем вам, что делать, если в вашем анализе крови обнаружены атипичные лимфоциты, поведаем о причинах, которые могли спровоцировать их рост.
В чём проявляется атипичность лимфоцитов?
Как известно, лимфоциты участвуют в процессах иммунного ответа — то есть, одни из первых бросаются на борьбу с опасными микроорганизмами. В результате этой борьбы они могут приобретать следующие параметры:
- Нестандартный внешний вид
Обычно лимфоцит имеет круглую форму и ровные границы. Атипичные лимфоциты отличаются рваными контурами и неправильной многоугольной структурой.
В нормальном состоянии размер лимфоцита не превышает 12 мкм. Увеличение этого показателя говорит о его атипичности.
Воздействие патогенных организмов распространяется также и на ядро клетки — если посмотреть на неправильный агранулоцит через микроскоп, можно обнаружить, что оно вытянуто, удлинено, испещрено продолговатыми трещинками.
Атипичные лимфоциты также имеют более яркий окрас, при добавлении в анализируемую кровь красителя гематоксилина — это также один из способов выявления необычных клеток.
А вы знали, что черты характера человека влияют на его уровень сопротивляемости болезням? Есть исследование, подтверждающее, что активные и уверенные в себе люди вырабатывают большее количество клеток иммунного ответа, что и помогает им бороться с болезнями. Таким образом, оптимистичный и положительно настроенный человек имеет меньше поводов для беспокойства о своём здоровье.
Причины появления атипичных лимфоцитов
Многие люди, напуганные различными статьями в интернете и медицинских справочниках, уже на рефлекторном уровне начинают паниковать при виде слов «атипичный», «неправильный» и «мутагенный», ассоциируя их с онкологическими заболеваниями. Не спорю, повышенное число лимфоцитов, как и появление атипичных лимфоцитов, может являться косвенным симптомом рака, но это лишь одна из возможных причин, причём не самая распространённая.
Гораздо чаще к усилению выработки лимфоцитов приводит какая-либо инфекция или же аллергическая реакция. Такое явление называют лимфоцитозом. Медики различают три разновидности данного заболевания: реактивный, постинфекционный и злокачественный. Первые два связаны с ослаблением функций организма в результате инфекции, третий — с наличием опухолевого процесса в организме.
Лимфоцитоз неизбежно ведёт к образованию неправильных лимфоцитов, а точнее, он является одним из факторов, сопутствующих данной патологии. Причин у неё может быть несколько:
- Приём определённого круга лекарственных препаратов (к примеру, иммунных сывороток органического происхождения);
- Инфекционные заболевания: пневмония, ветрянка, гепатит и т.д.
- Бруцеллёз — заболевание, поражающее домашних животных. Попадая в организм человека через продукты питания, может вызывать нарушение в работе различных систем, в том числе и иммунной;
- Токсоплазмоз — заболевание без явной клинической картины, поражающее, однако, иммунные клетки организма и приводящее к возникновению реактивных лимфоцитов;
- Лимфолейкоз — злокачественное поражение лимфатических узлов, характеризующееся накоплением в них раковых клеток;
- Коклюш — заболевание дыхательных путей, сопровождаемое судорожным кашлем. Чаще всего встречается у детей;
- Сывороточная болезнь — аллергия на препараты животного происхождения;
- Сифилис на некоторых стадиях.
Уровень агранулоцитов в крови определяется общим анализом крови (на тромбоциты, эритроциты и лейкоциты). Сдаётся такой анализ обычно с утра и на голодный желудок.
Стоит отметить, что в крови взрослого человека можно обнаружить атипичные лимфоциты и при отсутствии патологического процесса в организме, поэтому так важно проконсультироваться с врачом насчёт результатов вашего анализа — именно он первым заметит неладное и посоветует, что делать в сложившейся ситуации.
Ещё одним немаловажным фактором развития атипичных агранулоцитов является аллергия. Врачи по всему миру твердят о том, что аллергические реакции станут одной из главных проблем, преследующих городских жителей в XXI веке.
Дело в том, что в условиях экологических катаклизмов и загрязнённости воздуха, иммунная система человека начинает работать неправильно, «сбоить».
Официальная статистика показывает, что уже сейчас число болеющих аллергией детей составляет 15%!
Норма атипичных лимфоцитов и лечение
В организме здорового человека может содержаться до 6 % атипичных лимфоцитов, большая часть из них консолидируется в кровеносной системе. Стоит встревожиться, если этот уровень превышает 7-10%, именно на это и необходимо указать своему врачу.
https://youtube.com/watch?v=ObSIspnvI2k
Лечение атипичных лимфоцитов, естественно, заключается в выявлении первопричины, а до тех пор не стоит прибегать к каким-то серьёзным мерам.
Чаще всего врачи назначают:
- Витаминно-минеральную терапию, укрепляющую иммунитет.
- Если заболевание имеет вирусную природу, соответственно назначаются антибиотики и противовирусные препараты.
- Антигистаминные и противоаллергические лекарства, если образование атипичных лимфоцитов спровоцировано аллергией.
Не стоит забывать также и о правильном питании, здоровом образе жизни и других мероприятиях, направленных на укрепление организма.
Резюмируя:
Лимфоциты — это группа иммунных клеток крови, подвид лейкоцитов, участвующая в борьбе организма с инородными телами и вирусами.
Когда иммунная клетка сталкивается с серьёзной проблемой, его структура, размер и цвет могут меняться, и тогда можно говорить о развитии его атипичности.
Норма атипичных лимфоцитов в крови человека составляет 6%, всё, что выше — свидетельствует о негативных изменениях в работе организма. Эти нарушения, в свою очередь, могут быть вызваны как вирусами, так и опухолевыми процессами, требующими немедленного лечения.
На этом всё, следите за состоянием своего организма, ведите здоровый образ жизни и не пускайте на самотёк имеющиеся проблемы, именно в этом и заключается секрет крепкого здоровья. Удачи!
Атипичные лимфоциты в анализе крови: что это такое и почему появляются?
Что делать, когда в анализе крови обнаруживаются атипичные лимфоциты? Данный вопрос беспокоит многих людей, получивших результаты исследования биологического материала, сданного на анализ.
Если и вы хотите получить ответ на вопрос и узнать про причины появления атипичных лимфоцитов, то читайте статью.
Общая информация
Лимфоцитами называют разновидности клеток крови, отвечающих за защитные процессы организма при его поражении различными заболеваниями.
Атипичные лимфоциты являются модификацией «стандартных» белых кровяных телец, отличающихся размерами и «рабочими» свойствами.
В идеале у здорового взрослого человека или ребенка количество лимфоцитов в крови должно попадать в границы пределов референтной нормы.
Количество телец значительно возрастает тогда, когда организм пациента приступает к борьбе с какой-либо проблемой, поражающей ткани, органы или иммунную систему.
Состояние, при котором лимфоциты повышены, называют лимфоцитозом. Иногда патология может наблюдаться и у внешне здоровых людей, не имеющих жалоб на какие-либо проблемы с самочувствием.
В таком случае при выявленном и подтвержденном повторными анализами лимфоцитозе пациентам следует посетить профильного врача – гематолога, занимающегося исследованием патологий крови.
Атипичные лимфоциты бывают различных видов. Данные виды названы в честь врачей, исследовавших болезни крови и впервые обнаруживших тот или иной вид атипичных клеток.
Первая группа атипичных телец называется клетками Дауни. Впервые они были выявлены в первой трети двадцатого века у пациентов, страдающих от патологий, спровоцированных наличием цитомегаловируса или вируса Эпштейна-Барра.
Вторая группа атипичных лимфоцитов названа в честь известного гематолога Ридера, исследовавшего различные патологии крови своих пациентов.
Ридер выявил, что у многих из тех, кто страдали от острой лейкемии, лимфоциты приобретают иное строение.
В частности, ядра таких лимфоцитов словно разделены пополам и обладают неравным контуром. Иногда тельца данной группы называют амитотическими.
READ Диагностика крови — уровень фибриногена повышен
Третья группа атипичных лимфоцитов называется клетками Боткина-Клейна-Гумпрехта. Основное заболевание, провоцирующее появление данных атипичных телец, – лимфаденоз.

Клетки данного вида не обладают какими-либо полезными функциями, но при этом постоянно находятся в крови пациентов, страдающих от патологий. В некоторых медицинских источниках можно встретить альтернативное название данных атипичных лимфоцитов, звучащее как «тени Боткина-Клейна-Гумпрехта».
Разновидности атипичных лимфоцитов
Атипичные лимфоциты появляются в организме под воздействием различных антигенов. Главной отличительной чертой является увеличенный размер клеток.
Для сравнения, размер «стандартных» телец колеблется в районе десяти – двенадцати микрометров, размер атипичных лимфоцитов составляет около тридцати микрометров.
Стандартные лимфоциты имеют характерную круглую форму, а лимфоциты, обладающие атипичным происхождением, могут видоизменяться, превращаясь в многоугольные клетки, обладающие неравномерными по длине рваными гранями.
Главные изменения, специфические для атипичных лимфоцитов, происходят внутри их ядер.
В ходе лабораторного исследования данных клеток можно обнаружить, что внутри них располагаются не обычные, гладкие и слегка удлиненные ядра, а ядра вытянутой формы, покрытые микротрещинами и небольшими вмятинами.
Анализ крови, направленный на выявление атипичных телец, предполагает использование специализированных реактивов, позволяющих правильно оценить окрас клеток.
В качестве дополнительных реактивов традиционно используются вещества, называемые «гематоксилином» и «эозином».
После взаимодействия с данными веществами лимфоциты атипичного вида, находящиеся в составе биологического материала пациента, взятого на анализ, приобретают темно-серый или синеватый цвет, причем их ядра окрашиваются в оттенки фиолетового цвета. Классические лимфоциты имеют жемчужный, слегка сероватый или желтоватый оттенок.
Повышенное количество лимфоцитов в крови пациента может быть спровоцировано различными факторами. Выделяют реактивный, постинфекционный и злокачественный лимфоцитоз.
Реактивный лимфоцитоз появляется вследствие значительно ослабленного иммунитета.
Организм, незащищенный даже от не самых значительных патологических ситуаций, порождает большое количество как обычных, так и атипичных телец, обладающих большими размерами и неспособных эффективно бороться с заявленными проблемами.
Постинфекционный лимфоцитоз является наиболее безопасным для человека, так как носит временный характер.
Основной причиной его появления называют вирусные или инфекционные заболевания, перенесенные в недавнем прошлом.
READ Факторы, из-за которых лимфоциты повышены в крови
Злокачественный лимфоцитоз – патологический симптом, характерный для людей, страдающих от каких-либо онкологических заболеваний.
Онкология стимулирует организм человека вырабатывать огромное количество лимфоцитов, часть из которых перерождается в атипичные клетки.
Причины появления
Если анализ крови покажет присутствие в биологическом материале атипичных лимфоцитов, то не стоит паниковать и думать о плохом.
В подавляющем большинстве случаев их нахождение будет оправдано недавно перенесенными вирусными заболеваниями или различными аллергическими процессами, протекающими в тканях организма.
Чтобы нивелировать проблему и не спровоцировать развитие более серьезных патологических ситуаций, следует заняться восстановлением иммунной системы.
:
После ее восстановления иммунитет перестанет производить на свет неполноценные, атипичные кровяные тельца и вновь будет готов к борьбе с возможными заболеваниями.
Однако в некоторых случаях наличие атипичных телец в крови у ребенка или взрослого может указывать на ряд достаточно серьезных патологий, которые требуют либо незамедлительного (и зачастую радикального) лечения либо тщательного контроля врача над их течением.
Речь идет о таких патологиях, как:
- лимфолейкоз (поражение лимфатической системы раковыми клетками);
- бруцеллез (заболевание инфекционного спектра, передающееся людям от контакта с животными и негативным образом сказывающееся на правильной работе нервной и сердечно-сосудистой систем);
- сифилис (инфекция, поражающая слизистые ткани, костную и нервную систему);
- токсоплазмоз (заболевание, не имеющее ярко выраженных симптомов, но при этом в острой форме разрушающее все системы организма);
- пневмония, ветрянка, гепатит и проч.
Кроме того, появление атипичных лимфоцитов в организме человека может быть вызвано длительным лечением каких-либо патологий, в ходе которого использовались специализированные сыворотки животного происхождения, предназначенные для повышения радикально ослабленного иммунитета.

Данные сыворотки могут восприниматься телом пациента, получающего лечение, в качестве инородных реагентов, поэтому его организм может начать бороться с компонентами, входящими в их состав, используя остатки собственной, но изрядно истощенной иммунной системы.
READ Показатели нормы лимфоцитов в крови у женщин
Лабораторные анализы и лечение проблемы
Чтобы выявить наличие или отсутствие атипичных лимфоцитов в биологическом материале пациента, врачи направляют человека на сдачу общего анализа крови, подразумевающего детальное исследование уровня и разновидностей лейкоцитов, эритроцитов, лимфоцитов и тромбоцитов.
Чтобы получить направление на анализ, следует посетить терапевта – врача общей практики, или гематолога – доктора, специализирующегося на лечении заболеваний крови.
Впрочем, дать направление на данный анализ могут и другие профильные врачи в том случае, когда заподозрят у пациента, жалующегося на определенные симптомы, какие-либо проблемы со здоровьем, предполагающие наличие атипичных телец.
Состояниям, для которых характерно появление атипичных лимфоцитов в крови, в одинаковой степени подвержены как взрослые люди, так и маленькие дети, обладающие сниженным иммунитетом, не способным самостоятельно, без помощи лекарственных средств, бороться с возникающими заболеваниями.
:
Лечение проблемы, для которой характерно повышение данного показателя, симптоматическое и зависит от вида патологии-катализатора процесса выработки атипичных лимфоцитов.
Если причиной всему – аллергия, то больным назначают прием антигистаминных препаратов.
Тогда, когда появление атипичных телец вызывается различными бактериальными инфекциями, используют антибиотики узкого или широкого спектра действия.
При наличии более серьезных патологий у пациентов им назначают комплексное лечение, состоящее из нескольких фаз.
Лимфоциты атипичного вида, обнаруженные в общем анализе крови – повод для проведения дополнительных уточняющих исследований биологического материала.
В норме они должны отсутствовать в человеческом организме. Чтобы исключить риск появления или прогрессирования каких-либо патологических ситуаций, для которых характерно появление данного показателя, следует внимательно прислушиваться к рекомендациям лечащего врача.
Вы здесь:
10579 0
Атипичные лимфоциты: норма в анализе крови у взрослых и детей, причины повышения — Опухоли нет
Противостоять болезням организму помогают антитела. Их выработка происходит в костном мозге. Здесь идёт созревание лимфоцитов, нейтрофилов, базофилов, эозинофилов, моноцитов. Больше всего образуется лимфоцитов – главных борцов иммунной системы, которые занимаются защитой организма.
Наряду с ними существуют клетки с особыми параметрами, функциями. Атипичные лимфоциты – это разновидность иммунных тел. Причиной их появления становятся аллергические реакции, инфекции. Воздействие патогенных организмов меняет их структуру, форму. При нормальном состоянии человека они отсутствуют.
Разного рода заболевания провоцируют их появление.
Атипичные мононуклеары (вироциты) в крови у взрослых и детей
Атипичные мононуклеары или вироциты — разновидность лимфоцитов, клеточная структура которых имеет сходство с моноцитами. Они имеют одноядерное строение. Появление в крови может указывать на развитие инфекционного вирусного заболевания. Если при этом наблюдается изменение количественного показателя крови, это указывает на прогресс вируса в организме.
Важно! В данном случае проводится дополнительное обследование, так как атипичные мононуклеары характерны для инфекционного мононуклеоза.
Факторы появления вироцитов в крови
Причиной возникновения мононуклеарных клеток в крови является попадание в организм человека вирусной инфекции.
Важно! Когда человек полностью здоров, атипичные мононуклеары в крови составляют минимальный процент или вовсе отсутствуют.
Когда уровень вироцитов в анализе крови составляет более 10%, данное состояние может спровоцировать:
- инфекционное, вирусное заболевание в острой форме (в частности, мононуклеоз, ветряная оспа);
- вакцинация (как ответная реакция организма на введение фрагментов вируса).
Примечание: мононуклеары атипичные в начале развития патологии увеличивают свою численность вместе с другими видами клеток (палочкоядерными нейтрофилами), в то время как концентрация сегментоядерных клеток уменьшается.
Атипичные мононуклеары в крови у ребенка, как правило, вызваны вирусом Эпштейна-Барра, поражающим верхние дыхательные пути, шейные лимфоузлы.
Высокая концентрация вирусных клеток наблюдается на поверхности глотки, в тканях печени, селезенки, лимфоузлах.
Поэтому после инкубационного периода, длящегося от 5 до 15 суток, нередко отмечается увеличение размеров селезенки и печени.
Инфекционный мононуклеоз причисляют к вирусам группы герпесов 4 типа.
Симптомы, характерные при увеличении уровня мононуклеарных клеток у детей
Дети первого года жизни наименее подвержены заболеванию Эпштейна-Барра. Объясняется это наличием врожденного пассивного иммунитета к данному вирусу.
Однако у детей в 7–10 лет отмечается снижение защитных функций организма, в связи с чем у пациентов данной возрастной группы нередко обнаруживаются атипичные мононуклеары в общем анализе крови.
В этом возрасте зарегистрировано наибольшее число заболеваний инфекционным мононуклеозом.
Симптомы, которые являются признаком повышения вироцитов в крови у ребенка:
- гипертермия (высокая температура тела — 380 и выше);
- усиленное потоотделение;
- уплотнение, увеличение лимфатических узлов (в шейной области);
- налет белого цвета на миндалинах;
- набухание небных миндалин;
- количественное изменение химического состава крови (изменение лимфоцитарной формулы);
- увеличение размеров печени, селезенки.
Вас также могут заинтересовать нормы содержания лимфоцитов в крови у женщин и прочитать о них можно в следующей статье на нашем портале.
Примечание: согласно статистическим данным более подвержены инфекционному мононуклеозу мальчики в возрасте до 10 лет.
Признаками инфицирования может быть кожная сыпь, имеющая петихиальный характер и различную локацию.
Признаки повышения атипичных мононуклеаров у взрослых
Клинические проявления начальной стадии патологии у взрослых:
- упадок сил;
- тошнота;
- катаральные явления — отечность носоглотки, затрудненное носовое дыхание, сиплость голоса, прочее;
- гнойные образования на задней стенке гортани;
- озноб, резкое повышение температуры;
- ноющая боль в суставах, мышцах.
Основными проявлениями патологий, при которых возрастает численность атипичных мононуклеаров, являются:
- проявления интоксикации (тошнота, потоотделение, озноб, прочее);
- набухание лимфоузлов;
- одновременно увеличение размеров селезенки, печени;
- мигрень;
- усиление боли в суставах, мышцах;
- появление симптомов ангины (гиперемии слизистой неба, желтый налет рыхлой структуры на небных миндалинах, боль в горле).
Примечание: может наблюдаться отечность лица по причине нарушенного лимфооттока. Лимфоузлы могут увеличиваться до 5 см в диаметре. При пальпации болезненные ощущения либо незначительны, либо вовсе отсутствуют.
В активной фазе мононуклеоза увеличивается печень и селезенка. При этом нередко возникает желтушный синдром со следующими проявлениями:
- тошнота, доходящая до рвоты;
- снижение, отсутствие аппетита;
- изменение цвета мочи (потемнение, мутность);
- тянущая боль, чувство распирания в подреберье с правой стороны;
- желтый оттенок кожных покровов, глазного белка;
- расстройство стула (запор, диарея).
Спустя 10-12 дней после появления первых симптомов по телу может распространиться пятнисто-папулезная сыпь неопределенной локализации, которая не вызывает зуда.
Болезни, при которых возрастает уровень атипичных клеток
Атипичные мононуклеары в общем анализе крови являются признаком инфекции в организме. Точный диагноз можно установить исходя из следующих критериев форменных клеток:
- изменение структуры и формы;
- увеличение количества;
- изменение процентного соотношения между разными видами клеток.
Примечание: содержание вироцитов в пределах 10-15% с большой вероятностью указывает на развитие инфекционного мононуклеоза.

При каких заболеваниях характерны атипичные мононуклеары? Это может быть токсоплазмоз, вирус герпесной группы, ВИЧ, онкологические патологии, прочее.
Нередко отмечается превышение нормы содержания после введения вакцины у детей.
-передача «Жить здорово» о симптомах и лечении инфекционного мононуклеоза